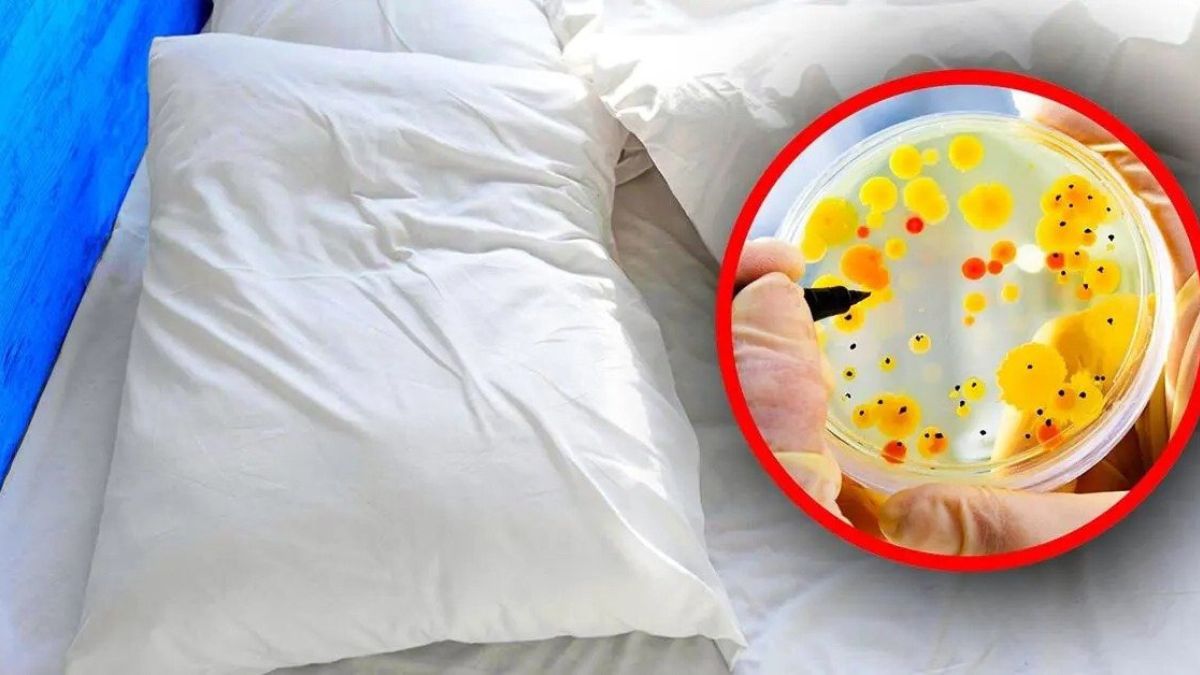

Au fil des jours, des quantités considérables de saleté et de bactéries se multiplient dans nos draps. Le corps humain transpire pendant le sommeil (encore plus quand il fait chaud) et les draps se transforment ainsi en bouillon de culture. Au bout de combien de jours les draps doivent-ils être changés ?
Il est certain qu’il ne faut pas attendre trop longtemps pour changer les draps, au risque de voir se multiplier les acariens et de souffrir de maladies respiratoires et d’allergies. Pour se protéger au mieux tout en profitant d’une bonne nuit de sommeil, il est important de garder les draps propres. La question se pose donc : à quelle fréquence faut-il les laver ?
À quelle fréquence faut-il laver les draps pleins de poussière et de bactéries ?
Selon Philip Tierno, microbiologiste à l’Université de New York, la prolifération des acariens pourrait provoquer des maladies.Ces petits arachnides microscopiques sont présents en grande quantité dans les draps pendant une semaine. Il recommande donc de laver les draps une fois par semaine si l’on part du principe que vous dormez tous les jours dans votre lit. Si vous dormez seul, prenez une douche chaque nuit et portez un pyjama, il est également approprié de le faire une fois toutes les deux semaines ou plus.
D’autre part, selon les cas, il peut être nécessaire de laver les draps plus d’une fois par semaine. Ainsi, si vous mangez occasionnellement au lit ou si vous avez des animaux domestiques, vos draps devraient être lavés tous les 3-4 jours. Et ce sera d’autant plus le cas si vous les faites dormir dans votre lit.
Laver les draps:
Même si vous souffrez d’asthme ou d’allergies, il est conseillé de laver vos draps plus souvent que d’habitude. Cette habitude peut vous aider à voir si vous vous sentez mieux.
- Il est également recommandé de laver les draps plus souvent pendant la saison estivale, car la transpiration pénètre davantage dans les draps. Nous préférons également laver les draps plus souvent si nous avons des allergies saisonnières en été ou au printemps.
- Pour garder vos draps propres, vous devez savoir comment les laver correctement. Pour ce faire, voici quelques étapes simples à suivre :
- Commencez par lire attentivement l’étiquette du drap pour connaître les instructions spécifiques au tissu. Lavez ensuite les draps avec le programme le plus chaud de la machine et utilisez un détergent doux. Il est également recommandé de rincer les draps une seconde fois afin d’éliminer le moindre résidu de détergent. Ceci afin de vous protéger si vous avez la peau sensible. Ensuite, suspendez vos draps pour les faire sécher.
- Pensez également à apporter un jeu de draps pour le lavage, car l’opération peut prendre du temps. Vous pouvez donc tout aussi bien en profiter pour avoir une réserve de draps propres afin de rendre le travail plus gérable. Ainsi, lorsque le moment sera venu de changer votre lit, vous aurez déjà un drap propre prêt pour vous.
À quelle fréquence les oreillers doivent-ils être lavés?
S’il est si important de garder vos draps propres, le reste de votre literie devrait bénéficier de la même attention. Et pour cause, les champignons et les bactéries pénètrent également dans nos oreillers.
Mettez vos taies d’oreiller avec les draps dans la machine à laver et si vous avez une peau sensible et sujette à l’acné, il est conseillé de les laver tous les trois jours. Pour les oreillers, il est conseillé de les laver tous les trimestres, voire tous les six mois, et idéalement de les changer tous les ans.
À quelle fréquence les draps doivent-ils être lavés ?
Ne vous inquiétez pas, contrairement à vos draps et oreillers, vous laverez moins souvent les housses de couette et les couvertures . Pour tenir les germes à distance, suivez ces conseils :
- Les couvertures doivent être lavées tous les trimestres. Les couvertures en polaire peuvent être lavées en machine à 60°, les couvertures en acrylique à 30° en activant le lavage délicat et en réduisant l’essorage. Il est possible de les faire sécher en machine, mais à basse température.
- Le protège-matelas : la fréquence de lavage d’un protège-matelas peut dépendre de certains paramètres. En général, il est conseillé de le laver tous les deux mois, mais il sera nécessaire de le faire plus souvent si vous avez un animal domestique ou s’il est taché.
- Le matelas : aspirez le matelas tous les 1 à 2 mois avec une brosse douce.
- Les couettes : Un nettoyage en profondeur est recommandé au moins deux fois par an.
Toutes ces informations devraient donc nous encourager à laver et à remplacer nos draps et autres articles de literie le plus régulièrement possible. C’est aussi un geste qui profite à son mode de vie et à sa santé.